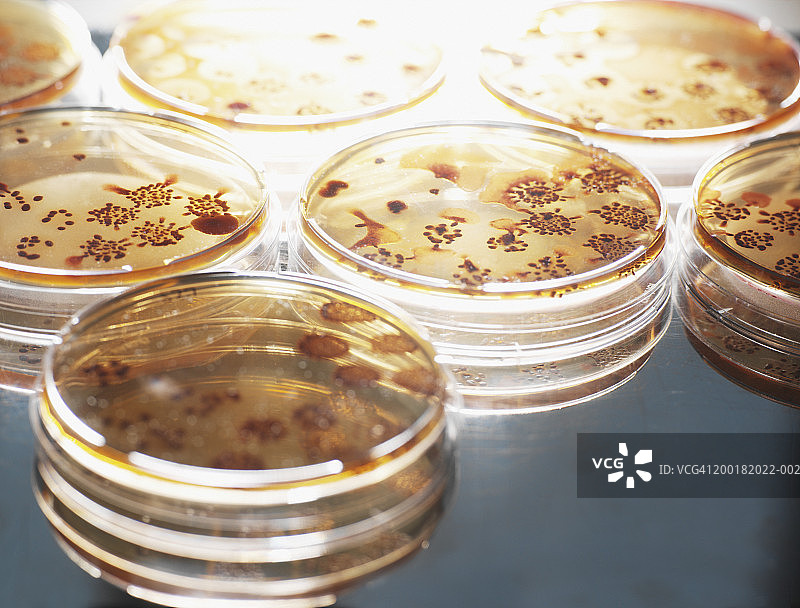
培养皿中琼脂培养的微需氧生物特写图片素材

图片
- 图片
- 视频
- 音频
- 字体
培养皿中琼脂培养的微需氧生物特写
培养皿中琼脂培养的微需氧生物特写图片素材作品是由视觉中国旗下网站(VCG.COM)的图片品牌合作方:DigitalVision提供,作品作者是:Henrik Sorensen/视觉中国;图片ID:VCG41200182022-002;最大规格:4796 x 3647 px (300ppi) | TIFF 50.04 MB;存储大小:2.90 MB - JPG;授权方式是:;当前图片素材提供下载与正版授权服务,助力您的品牌提升。
图片ID:VCG41200182022-002
品牌:DigitalVision
最大尺寸:4796 x 3647 px (300ppi) | TIFF 50.04 MB | 40.61 x 30.88 cm (15.99 x 12.16 in.)
存储大小:2.90 MB - JPG
版权声明:本网站内容受《中华人民共和国著作权法》等法律保护。
经版权人或相关权利人授权,本网站有权就该内容的使用与其他第三方签署许可使用协议。
如您需获取本网站内容,请与本网站沟通具体使用细节并签署许可使用协议。
未经许可使用本网站内容,则可能面临构成侵权并承担侵权赔偿责任等法律风险。
购买咨询
